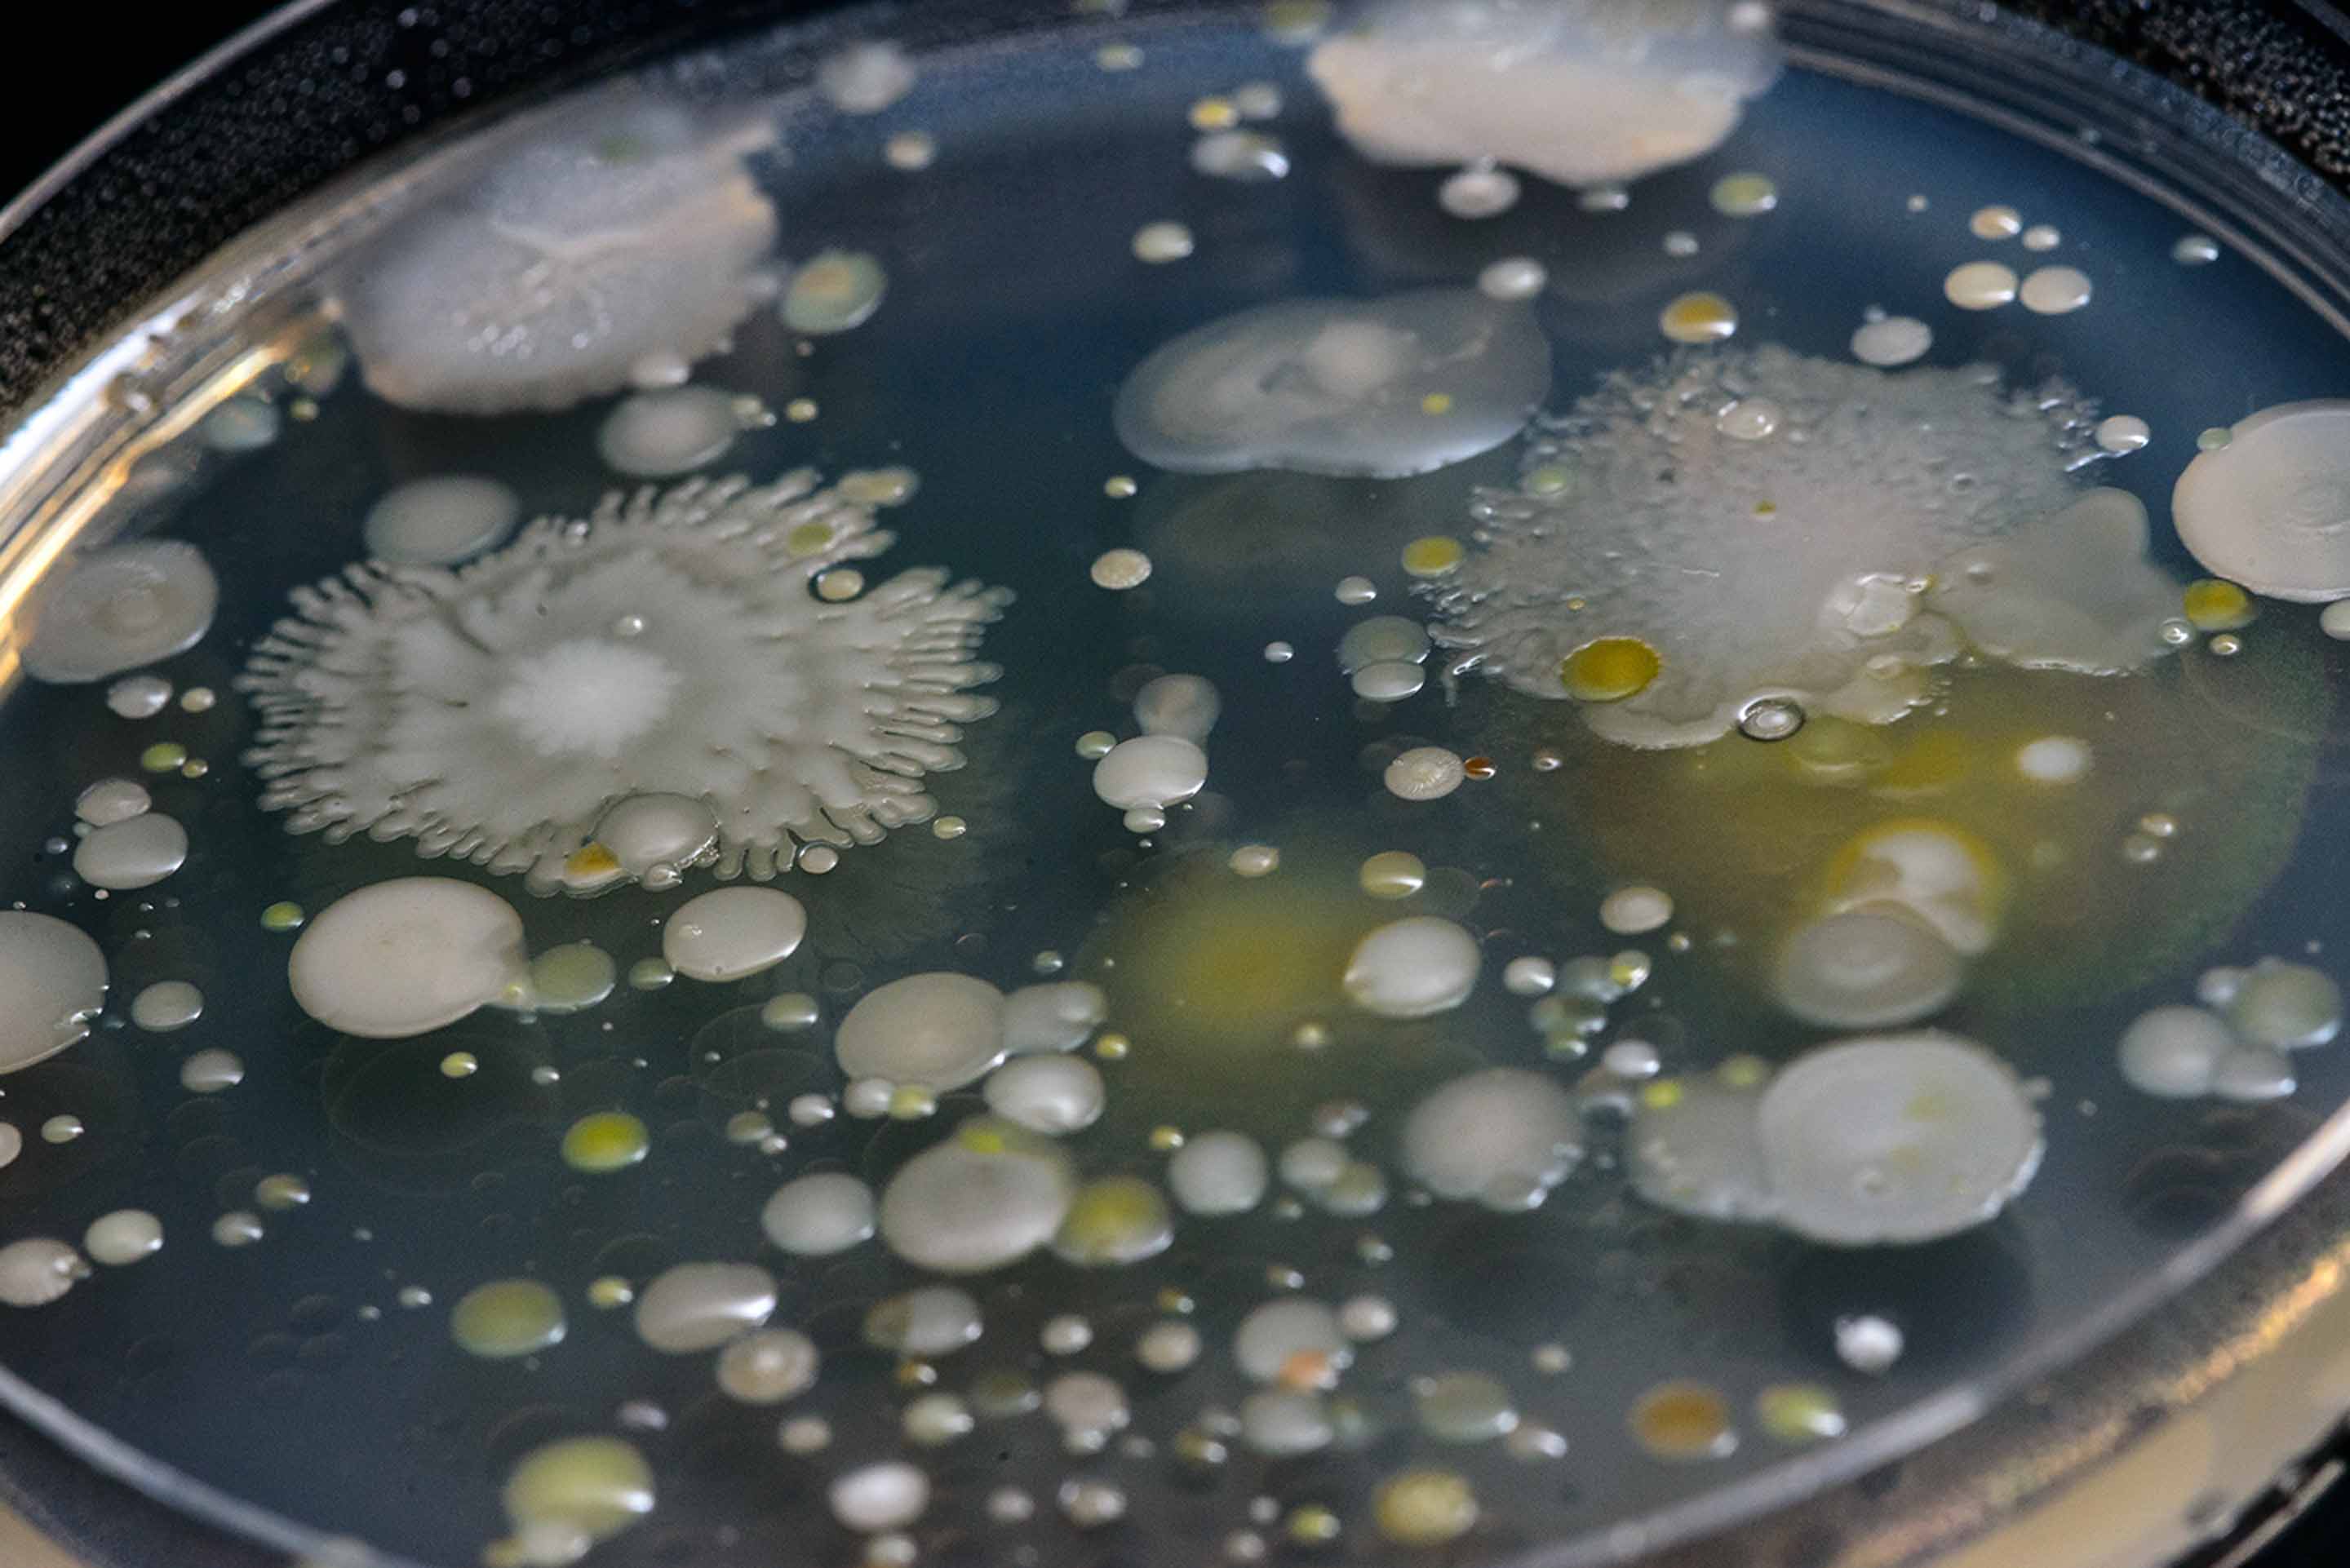

There isn’t a major challenge facing society that doesn’t have Michigan State University Spartans working on a solution. And while research and discovery at the university span a vast collection of disciplines, one question drives MSU researchers: ‘What if?’
Supported by a best-in-class research infrastructure and partnerships built to last, Spartans turn this simple question into pioneering solutions that make our world smarter, healthier, safer and better for all.
Loading component...
Asking unconventional questions
Could determining how an octopus’s brain interacts with its dominant tentacle improve how the next generation of human prosthetic devices are developed? Using some of the most sophisticated machines on the planet, Spartan researchers at the Institute for Quantitative Health Science and Engineering are working together to answer questions few have thought to ask yet.
Discovery machine
Above and below the surface of MSU’s campus, the Facility for Rare Isotope Beams is taking shape as the world’s most powerful rare isotope accelerator. A core piece of the nation's research infrastructure, this U.S. Department of Energy Office of Science discovery machine will fuel breakthroughs in medicine, national security and industry, while answering big questions about the origins of our universe. Home to the top nuclear physics graduate program in the United States, MSU also is shaping the next generation of nuclear scientists who will advance rare isotope research for generations to come.
Food for the future
Some of the top plant scientists in the world are creating solutions that make many of the most nutritious crops on earth more resilient in the face of plant diseases, droughts and rising temperatures. Applying principles found in disciplines like evolution and engineering, MSU researchers are working to improve the process of photosynthesis in plants and protect them at the cellular level.
Beyond the box
From protecting precious cargo like rockets to reducing packaging waste with biodegradable coffee lids to ensuring high-tech medical equipment stays secure en route to patients, MSU’s top-ranked packaging school creates safer, smarter, more sustainable solutions for the goods we depend on. More great news: MSU prepares more than half of all packaging graduates employed in the United States, creating solutions that deliver.
Top of the supply chain
Top-ranked nationally, MSU’s powerhouse supply chain management programs are changing the way the world makes business happen. Crossing disciplines and industries, MSU experts address big problems, from helping hospitals save millions of dollars annually by adopting more streamlined operating room procedures to teaming up with conservationists to disrupt illegal supply chains used in the trafficking of wildlife.
Outsmarting antibiotic resistance
Wiping out dangerous bacteria with antibiotics isn’t the only solution for keeping people, animals and crops healthy. Researchers at MSU are looking at this critical threat from every angle, and one of their innovative solutions includes disarming, rather than destroying, these invisible dangers.
Powering sustainable change
MSU’s 5,300-acre campus is the ideal laboratory for building a greener future. The university’s gold-rated sustainability efforts range from installing green roofs on bus stop shelters and reducing food waste in dining halls to generating power for MSU’s city-sized campus with the help of the largest solar carport array in North America. Covering 5,000 parking spaces, it produces 15,000 megawatt hours of solar energy each year — enough to power approximately 1,800 homes.
Photography by Kurt Stepnitz